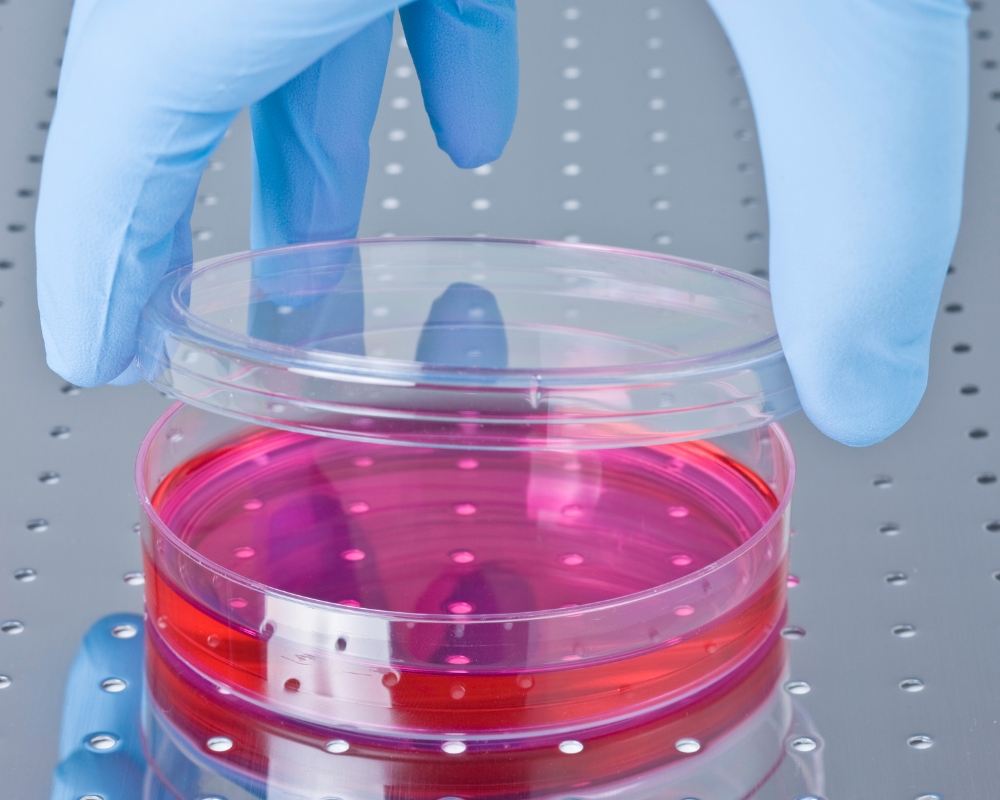

Chi phí cấy ghép tế bào gốc ở Việt Nam bao nhiêu
Chi phí cấy ghép tế bào gốc Việt Nam bao nhiêu? Đây là câu hỏi được nhiều người quan tâm khi tìm hiểu về phương pháp điều trị hiện đại và đầy tiềm năng này. Cấy ghép tế bào gốc đang ngày càng được ứng dụng rộng rãi trong y học để điều trị các bệnh lý như ung thư máu, thoái hóa khớp, hay tổn thương tủy sống. Tuy nhiên, bên cạnh hiệu quả điều trị, chi phí luôn là yếu tố khiến nhiều người cân nhắc trước khi quyết định. Trong bài viết này, hãy cùng Geneworld cập nhật về chi phí, cũng như các địa chỉ uy tín nhé.
Thực trạng nghiên cứu và ứng dụng tế bào gốc ở Việt Nam
Việc phát hiện ra tế bào gốc stem cell là một bước ngoặt mang tính cách mạng trong y học và sinh học hiện đại. Sự tồn tại của tế bào gốc - loại tế bào có khả năng tự tái tạo và biệt hóa thành nhiều loại tế bào chuyên biệt khác nhau đã mở ra hy vọng mới trong việc hiểu rõ cơ chế phát triển của con người, chữa lành tổn thương và điều trị nhiều bệnh lý nan y.
Giúp hiểu rõ hơn quá trình phát triển của cơ thể người
Tế bào gốc giúp các nhà khoa học nghiên cứu quá trình hình thành, phát triển và sửa chữa của các cơ quan và mô trong cơ thể.
Tạo nền tảng cho y học tái tạo
Phát hiện tế bào gốc là tiền đề cho các liệu pháp tái tạo mô và cơ quan bị tổn thương, thay thế các mô không còn chức năng do bệnh lý hoặc chấn thương.
Tiến bộ vượt bậc trong điều trị cá nhân hóa
Tế bào gốc cho phép phát triển các phác đồ điều trị được "cá nhân hóa" cho từng bệnh nhân dựa trên đặc điểm sinh học riêng biệt.
Tại Việt Nam, nghiên cứu và ứng dụng tế bào gốc đang có những bước tiến mạnh mẽ, đặc biệt trong các lĩnh vực y học tái tạo, điều trị bệnh lý và làm đẹp. Từ khoảng hơn một thập kỷ trở lại đây, nhiều cơ sở y tế lớn như Bệnh viện Truyền máu Huyết học TP.HCM, Bệnh viện Vinmec, Đại học Quốc gia TP.HCM hay Viện Tế bào gốc Trường Đại học Khoa học Tự nhiên… đã tiên phong nghiên cứu và phát triển các công nghệ liên quan đến tế bào gốc.
Một số thành tựu nổi bật bao gồm:
- Ứng dụng tế bào gốc từ mô mỡ và tủy xương trong điều trị thoái hóa khớp, tổn thương sụn, vết bỏng sâu và bệnh lý thần kinh.
- Ngân hàng lưu trữ tế bào gốc từ máu dây rốn đã được xây dựng tại nhiều bệnh viện lớn, phục vụ cho nhu cầu điều trị trong tương lai.
- Tế bào gốc đang được đưa vào liệu trình chăm sóc da tại nhiều spa, clinic với mục tiêu phục hồi, trẻ hóa làn da và điều trị sẹo mụn.
>>> Xem thêm: Tế bào gốc là gì? Nguồn gốc & khả năng chữa bệnh của tế bào gốc
>>> Xem thêm: Dùng tế bào gốc có tác dụng gì? Điểm danh tác dụng trong y khoa và làm đẹp
Ứng dụng tế bào gốc trong điều trị ở Việt Nam
Liệu pháp tế bào gốc trong điều trị ở Việt Nam đã và đang đạt được nhiều bước tiến đáng ghi nhận trong những năm gần đây. Từ chỗ chỉ là khái niệm mới mẻ, tế bào gốc nay đã trở thành một phần quan trọng trong một số phương pháp điều trị hiện đại tại các bệnh viện tuyến trung ương.
1. Ứng dụng tế bào gốc trong điều trị y khoa tại Việt Nam
Bệnh lý về máu: Bệnh viện Truyền máu Huyết học TP.HCM và Viện Huyết học - Truyền máu Trung ương đã thực hiện nhiều ca ghép tế bào gốc tạo máu điều trị bệnh bạch cầu, u lympho, đa u tủy.
Thoái hóa khớp và chấn thương xương khớp: Tế bào gốc từ mô mỡ hoặc tủy xương được ứng dụng điều trị thoái hóa khớp gối, khớp vai, hỗ trợ phục hồi sau phẫu thuật chỉnh hình.
Bệnh tim mạch: Một số nghiên cứu lâm sàng đã ứng dụng tế bào gốc trong điều trị bệnh nhồi máu cơ tim, giúp cải thiện chức năng tim.
Bệnh phổi tắc nghẽn mãn tính COPD: Năm 2019, Bệnh viện Phổi Trung ương đã thực hiện thành công ca truyền tế bào gốc để điều trị COPD làm chậm sự tiến triển của bệnh, cải thiện chất lượng cuộc sống của người bệnh, giảm các đợt cấp tính của bệnh.
Điều trị vết thương lâu lành, bỏng nặng: Tế bào gốc giúp tái tạo mô da, làm liền vết thương mãn tính nhanh hơn, đặc biệt trong các trường hợp loét do tiểu đường, loét tì đè, chấn thương nặng hoặc phẫu thuật lớn.

2. Ứng dụng trong thẩm mỹ - chăm sóc da và tóc
Tế bào gốc trong da liễu - thẩm mỹ: Nhiều chuyên khoa da liễu của bệnh viện tại các thành phố lớn đã đưa tế bào gốc vào các liệu trình trẻ hóa, căng bóng da, điều trị sẹo, nám da… Các sản phẩm như serum tế bào gốc, PRP kết hợp tế bào gốc cũng được áp dụng trong liệu trình phục hồi chuyên sâu.
3. Những bước tiến nổi bật
Đào tạo và nghiên cứu: Các trung tâm lớn như Đại học Y Dược TP.HCM, Bệnh viện Trung ương Huế, Viện tế bào gốc… đã triển khai nhiều đề tài nghiên cứu và hợp tác quốc tế về tế bào gốc.
Ngân hàng lưu trữ tế bào gốc: Hệ thống ngân hàng lưu trữ tế bào gốc từ máu và mô dây rốn ngày càng phát triển, giúp mở rộng khả năng sử dụng trong tương lai.
Ứng dụng tế bào gốc trong điều trị ở Việt Nam đang mở ra kỷ nguyên mới cho y học tái tạo. Dù còn cần thêm thời gian để hoàn thiện quy trình và nhân rộng, nhưng những thành quả bước đầu đã minh chứng tiềm năng to lớn của lĩnh vực này trong chăm sóc sức khỏe và sắc đẹp cộng đồng.
>>> Xem thêm: Tế bào gốc cho da mặt: Bí quyết trẻ hóa và phục hồi da từ gốc
>>> Xem thêm: Tế bào gốc stem cell giá bào nhiều? 05 hiệu quả ưu việt tế bào gốc mang lại
Chi phí ghép tế bào gốc Việt Nam
Ứng dụng cấy ghép tế bào gốc tại Việt Nam có chi phí khoảng vài trăm triệu, sau khi trừ bảo hiểm y tế, chi phí giảm xuống chỉ còn khoảng 40 triệu (theo thông tin ghép tế bào gốc tự thân điều trị một số bệnh huyết học tại nước ta). Trong khi đó, chi phí này có thể lên đến 7 tỷ đồng ở một số quốc gia như Mỹ.
Với chi phí cấy ghép tế bào gốc này, người bệnh dễ dàng được tiếp cận phương pháp hiệu quả, hiện đại, được giảm thiểu gánh nặng kinh tế trong quá trình điều trị.

Lý giải tại sao chi phí ghép tế bào gốc Việt Nam cao hơn nhiều so với các phương pháp khác là bởi vì liệu pháp tế bào gốc yêu cầu kỹ thuật cao, môi trường vô trùng nghiêm ngặt và chi phí bảo quản/ nuôi cấy tế bào với đội ngũ chuyên môn cao.
Một số cơ sở uy tín ứng dụng liệu pháp tế bào gốc Việt Nam có thể kể đến như: Bệnh viện Truyền máu Huyết học TP.HCM, Bệnh viện Đại học Y Dược, BV Trung ương Huế, Bệnh viện Trung ương Quân đội 108…
>>> Xem thêm: Tế bào gốc lấy từ đâu? Nguồn tế bào gốc phổ biến trong điều trị hiện nay
>>> Xem thêm: Lưu ý khi sử dụng tế bào gốc giúp tối ưu tính hiệu quả, an toàn
Lưu ý khi ứng dụng cấy ghép tế bào gốc
Để tránh trường hợp rủi ro và đảm bảo tính hiệu quả, an toàn trong điều trị với liệu pháp tế bào gốc, dưới đây là một số lưu ý:
1. Chỉ thực hiện tại cơ sở y tế được cấp phép
Cấy ghép tế bào gốc là kỹ thuật cao, đòi hỏi môi trường vô trùng tuyệt đối và đội ngũ chuyên môn cao. Vì vậy, liệu pháp cấy ghép tế bào gốc cần phải được thực hiện tại các bệnh viện được cấp phép hoạt động liên quan đến tế bào gốc.
2. Không áp dụng tùy tiện theo xu hướng
Không nên sử dụng tế bào gốc với mong muốn “trẻ hóa” hay “phục hồi” nếu không có chỉ định từ bác sĩ chuyên khoa. Cần tránh các quảng cáo sai lệch về khả năng “chữa bách bệnh” của tế bào gốc.
3. Phân loại đúng loại tế bào gốc sử dụng
Tế bào gốc tự thân (từ chính cơ thể bệnh nhân): thường an toàn hơn, ít nguy cơ thải ghép. Tế bào gốc dị thân (từ người khác): cần xét nghiệm tương thích HLA kỹ lưỡng để tránh phản ứng miễn dịch.

4. Theo dõi sát sau cấy ghép
Sau ghép, người bệnh cần được theo dõi các biểu hiện như: sốt, viêm, phản ứng miễn dịch, nguy cơ nhiễm trùng… Có thể cần nằm viện theo dõi từ vài ngày đến vài tuần tùy loại điều trị.
5. Đảm bảo nguồn gốc tế bào gốc minh bạch
Tế bào gốc phải được xử lý, bảo quản, kiểm định theo quy chuẩn sinh học nghiêm ngặt. Tuyệt đối tránh sử dụng sản phẩm trôi nổi, không rõ nguồn gốc.
6. Cân nhắc chi phí và hiệu quả thực tế
Cấy ghép tế bào gốc thường có chi phí cao và không phải lúc nào cũng mang lại hiệu quả như mong đợi. Cần được tư vấn kỹ về khả năng thành công, thời gian phục hồi, nguy cơ và chi phí trước khi quyết định.
>>> Xem thêm: Tiêm tế bào gốc và huyết tương giàu tiểu cầu PRP khác nhau thế nào
>>> Xem thêm: ADSC KIT tách chiết tế bào gốc từ mô mỡ được phòng khám, bệnh viện tin dùng
Qua bài viết này, Geneworld hy vọng đã giúp bạn hiểu rõ hơn về chi phí cùng các thông tin liên quan đến liệu pháp cấy ghép tế bào gốc Việt Nam, để từ đó có sự chuẩn bị phù hợp. Để tìm hiểu thêm về thông tin hữu ích về tế bào gốc, truy cập website geneworld.vn ngay!
Bài viết liên quan
Tiêm PRP khớp gối ở giai đoạn nào là tốt nhất?
Tiêm PRP khớp gối ngày càng được nhiều bệnh nhân và bác sĩ lựa chọn nhờ tính an toàn, ít xâm lấn và khả năng hỗ trợ tái tạo mô khớp. Tuy nhiên, hiệu quả của phương pháp này phụ thuộc đáng kể vào gi...
Chọn mỹ phẩm thiên nhiên lành tính “over hợp” với mọi loại da
Trong thời đại làm đẹp xanh - sạch lên ngôi, mỹ phẩm thiên nhiên ngày càng được ưa chuộng nhờ bảng thành phần lành tính và khả năng chăm sóc da bền vững. Tuy nhiên, không phải sản phẩm nào “thiên n...
Tần suất thoa kem chống nắng tối ưu hiệu quả bảo vệ da
Dưới tác động ngày càng khắc nghiệt của tia UV và ánh sáng xanh, việc chỉ thoa kem chống nắng một lần vào buổi sáng là chưa đủ để bảo vệ da. Không ít người dù dùng sản phẩm chống nắng chất lượng nh...